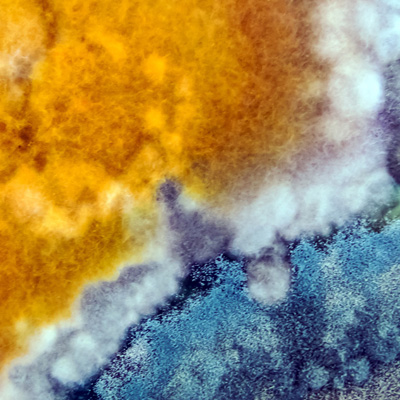

Who is this for?
The Mycotoxin Training Hub aims to deliver problem-specific, short-term courses and research opportunities tailored for actors of the agrifood industry. Our mission is to break the barrier between academia and industry to tackle challenges associated with mycotoxin contamination. Our ultimate goal is to safely and sustainably feed 9 billion people by 2050 while supporting 15 of the 17 Sustainable development goals.
Why was this launched?
With awareness of the challenges the agrifood chain faces today—and will face in the future—such as Brexit, regulatory changes, and climate change, Cranfield University launched the Mycotoxin Training Hub in 2021. This initiative addresses the urgent need for targeted and efficient training and research programmes across the agrifood chain.
Why Cranfield?
Cranfield is home to the applied mycology group, an internationally recognised Centre of Excellence in the application of fungal technology across the food, environment, and health sectors. With over 35 years of experience in mycotoxin management, this centre has established an excellent scientific reputation, supported by:
- 350+ scientific papers published,
- Extensive dissemination of research in industrial magazines, including: